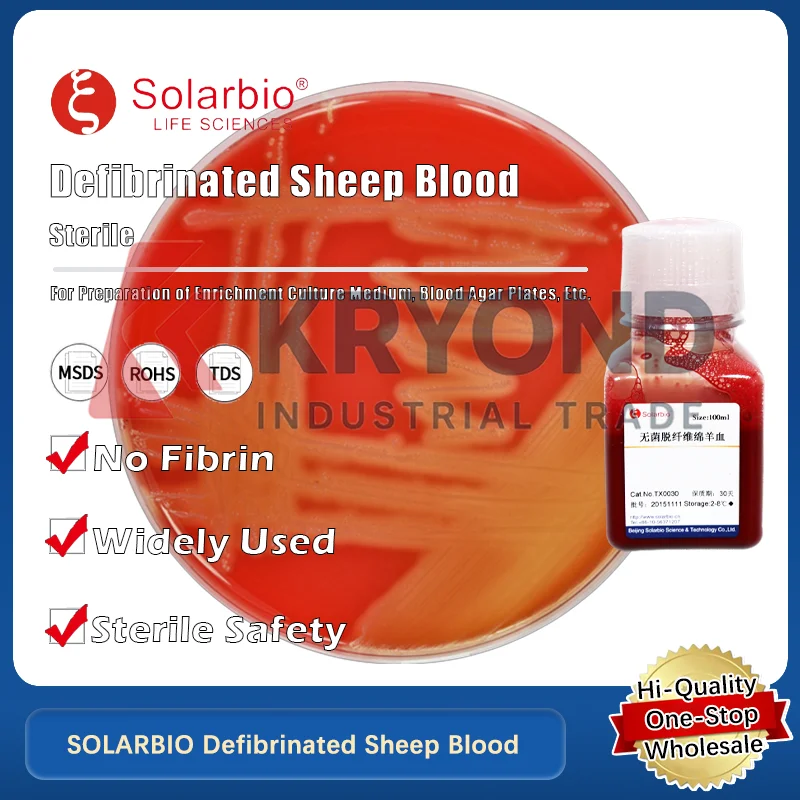
SOLARBIO Resazurin for Cellular Metabolism and Viability Assays in Laboratory Research Applications Original Product

For BMW R1200GS R1250GS LC ADV R1200 GS R 1250 GS Adventure 2013-2023 Side Tank Pad Oil Gas Fuel Protector Cover Sticker Decal
Price history chart & currency exchange rate
Customers also viewed

$27.57
Intelligent Charging DC Power Supply Variable,30V 10A Adjustable Switching Regulated DC Bench Power Supply,OCP OUTPUT Switch
aliexpress.com
$6.15
Barber Shop 20 Hats Mens Hats Hats Woman Baseball Caps Women's Baseball Cap Man Hat Baseball Cap
aliexpress.com
$8.75
Leather Protective Sleeve Case Pouch for IPhone iPad Pencil Stylus Pen Case Touch Screen Pen Cover Tablet Pen Holder
aliexpress.com
$6.67
Concise Design Hair Hoop Hair Band Round Rhinestone Accessories Bride Hair Band Bride Headwear
dhgate.com
$31.21
Fashion Women Denim Jacket Slim Lapel Jeans Button Ladies Short Coat Casual Long Sleeve Outwear Autumn Spring Loose Clothing New, Black
dhgate.com
$1.48
1pc Stainless Kitchen Gadgets Cut Onion Holder Fork Onion Cutter Slicer Tomato Potato Vegetable Cutter Kitchen Accessories.Q
aliexpress.com
$1.87
Затискачі для волосся «Алігатор» для укладання, стрижки та фарбування – Ідеально підходять для перукарів та домашнього використання
joom.com
$4.48
Classic Popular J-jokerS TV Movie Phone Case For IPhone 17 16 15 14 13 12 11 Pro MAX Matte Shockproof Back Anti Fall Matte Cover
aliexpress.ru
$18.60
GZE8U H75 GS35E Battery For HTC Google Pixel Desire One X S XC XL G23 8X H75 E9 4A 7 7A 8 728 Vive Version Pro Plus Ultra GS35E
aliexpress.com
$8.83
A74E-Water Tank Automatic Water Level Control Valve Switch Horizontal Inflow Installed Inside Tower Tank
aliexpress.com
$35.79
Dashboard Emergency Flashing Windshield Warning Light 12v Car LED Red/Blue Amber/White Signal Viper Strobe Flash Light
aliexpress.com
$1.27
2pcs Reinforcement Pull Aluminum Alloy Tie Stabilizer Hardware Corrosion Resistant Easy Install Replacement for Step Folding
aliexpress.com
$13.06
MTB Universal Mudguard 26/27.5/29inch Screw Fixed Widen Extension Mud Protector Against Splashing Water and Dirt Bicycle Fenders
aliexpress.com
$67.27
SOLARBIO Resazurin for Cellular Metabolism and Viability Assays in Laboratory Research Applications Original Product
aliexpress.com
$81.91
Vintage Men Suit Single Breasted Herringbone Short Man Tailcoat Notched Lapel Business Blazers Overcoat High Quality Customized
aliexpress.com
$13.02
Summer Skin Friendly T Shirt For Man Fashion Shoulder Spliced Design Short Sleeve Tee Shirt Men Slim Fit Casual Men's T-Shirts
aliexpress.com
$8.14
Жіноча зимова в язана шапка: Вітрозахисний, Теплий, Плюшевий захист вух, Вільний крій, Універсальний, Підходить для великих голів, Дизайн, що візуально робить обличчя худішим. One Size
joom.com











